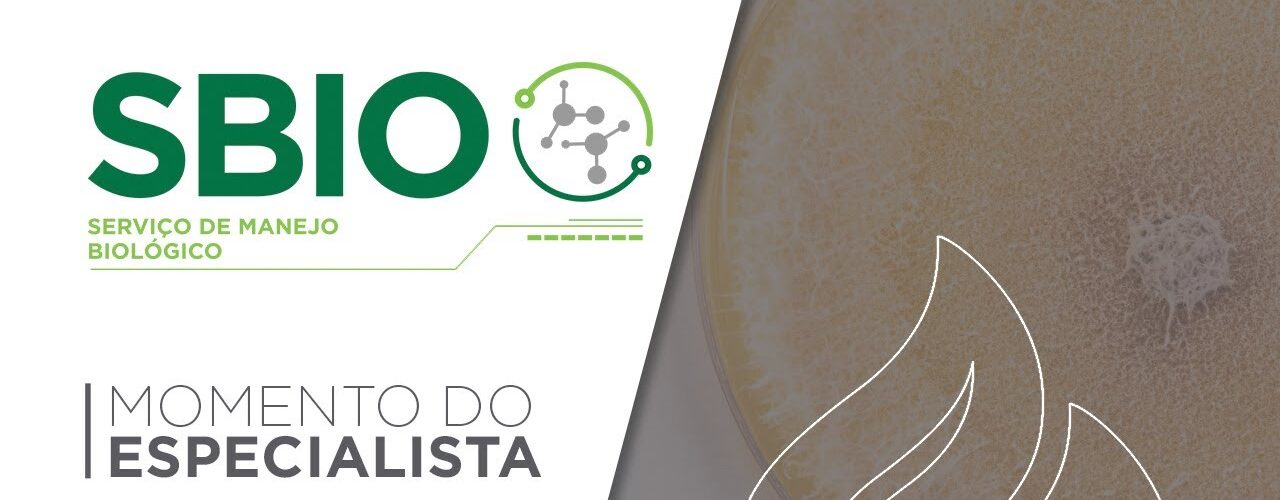

Com a crescente importância dos produtos biológicos na agricultura, entender a terminologia técnica se torna fundamental para os produtores. Dinalva Alves Mochi, especialista em produtos biológicos da Agroceres Binova explica de forma didática os conceitos de cepa, conídio e UFC no contexto dos microrganismos.
Cepa: A Identidade Genética dos Microrganismos
Cepa é um termo utilizado para descrever microrganismos da mesma espécie, porém com características genéticas ou bioquímicas distintas para uma função específica. Essas cepas são minuciosamente estudadas e selecionadas em laboratório para atender às necessidades específicas do produtor rural.
Conídio: O Ponto de Partida para a Vida
O conídio é uma pequena célula fúngica, frequentemente chamada de esporo fúngico. Sua principal característica é a capacidade de formar uma nova colônia. É, portanto, a unidade reprodutiva que dá início ao desenvolvimento do microrganismo.
UFC: A Medida da Eficácia
A Unidade Formadora de Colônia (UFC) é a unidade que quantifica a capacidade de um conídio viável de formar uma colônia. Em outras palavras, a UFC é a medida da viabilidade e da concentração dos microrganismos em um produto. A concentração de UFC por litro ou por mililitro é uma informação importante que o produtor deve verificar no rótulo dos produtos biológicos para garantir a eficácia da aplicação.

Adicionar Comentários